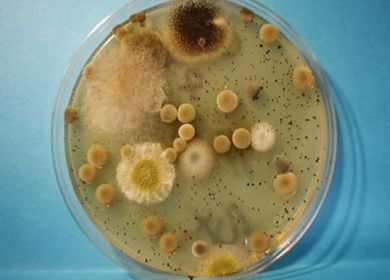

In Italia la penicillina sale più dello spread, da 2 a 24 Euro senza rimborso

Dettagli della notizia
Un altro piccolo grande scandalo italiano ci viene segnalato dalla dottoressa Cristina Reggini che Giovanni D’Agata, componente del Dipartimento Tematico Nazionale “Tutela del Consumatore” di Italia dei Valori e fondatore dello “Sportello dei Diritti”, riporta integralmente per evidenziare come in Italia si corra il rischio concreto che il diritto alla salute possa diventare un lusso per pochi.
Negli ultimi mesi un flacone di penicillina è aumentato del 1.200%, da 2 a 24 Euro, passando da mutuabile a fascia C, totalmente a carico del cittadino. La benzilpenicillina benzatinica, prodotta dalla Biopharma, da maggio 2011 è venduta in un nuovo formato, i due flaconi da miscelare sono stati sostituiti da una siringa già pronta per l’uso. Il nuovo packaging ha fatto lievitare il costo del farmaco al punto da renderlo proibitivo per il Sistema Sanitario Nazionale, che da mutuabile l’ha inserito in fascia C (a carico dell’assistito). La vicenda, nonostante leda il diritto alla salute di tanti cittadini, è passata quasi inosservata. Un mese fa se ne è occupata la trasmissione “Mi manda Rai Tre”, il 26 settembre scorso il Corriere della Sera, con la denuncia da parte di un cittadino, infine, il 10 agosto Repubblica dava voce ai dermatologi che lanciavano l&\#39;allarme sifilide.
Una ricerca sul web ha confermato la difficoltà di reperire il preparato sul territorio nazionale. Nel sito “Lettere al direttore” si leggono le testimonianze di cittadini rimasti, da un giorno all’altro senza alcuna comunicazione, privi del farmaco, sostituito poi da una versione “lusso”. In tutta Europa la benzilpenicillina continua ad essere venduta a pochi euro, così qualcuno si è rivolto a farmacie estere, in particolare a quelle Svizzere, della Repubblica di San Marino o del Vaticano. Gli appelli e le denunce affidati alla rete sono in gran parte di genitori che curano, con iniezioni di penicillina, la febbre reumatica o altre patologie dei loro bambini. Questo sarebbe già sufficiente per indignarsi, ma l&\#39;allarme lanciato dai dermatologi aggrava la situazione. La benzilpenicillina benzatinica è, tuttora, il principio attivo più efficace per il trattamento ambulatoriale della sifilide. Per la guarigione dalla malattia il protocollo prevede sei iniezioni, la cura, totalmente a carico del paziente, raggiunge i 144 euro. In questa vicenda di ordinaria follia una cosa è certa, il diritto alla salute dei cittadini, sancito nell’art. 32 della Costituzione, viene calpestato dagli interessi economici delle case farmaceutiche, nell’indifferenza delle istituzioni, che quel diritto dovrebbero tutelare.